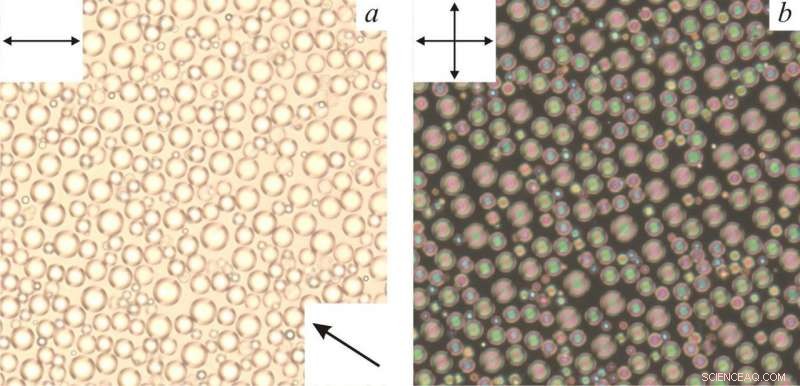
Researchers Uncover and Analyze Complex Defect Structures in Liquid Crystal Droplets

Droplets of a cholesteric liquid crystal as viewed through a polarizing microscope. Credit: Mikhail Krakhalev.
A team of scientists from Kirensky Institute of Physics of the Siberian Branch of Russian Academy of Science and Siberian Federal University (SFU) together with Russian and foreign colleagues studied droplets of a cholesteric liquid crystal that contained a twisted defect loop. The results of the study were published in Scientific Reports.
Liquid crystals (LCs) are chemical substances that enter mesophase (the state between solid matter and liquid) within a certain range of temperatures. Liquid crystals combine two opposite properties. They have fluidity typical of liquids, and anisotropy of physical properties characteristic of solid crystals (i.e., a difference in properties depending on direction). These peculiarities are explained by orientational order of long molecular axes. As a result, the molecules of an LC remain relatively mobile, but are oriented in a certain way determining the anisotropy of properties. Molecules may have different orientations, and may change under the influence of an electric field. That is why LCs are widely used in electrical optic devices, such as display screens.
The team worked with liquid crystals called cholesterics or chiral nematics. Each molecule of a liquid crystal has several rotation axes. In orientation structures, a predominant direction of long molecular axes is called a director. In case of cholesterics, the director forms a twisted helical structure. It means that the directions of long molecular axes (and therefore their dipole moment) are turned against each other at a certain angle, and their ends trace out a spiral line (a helix) around the axis of the helicoid.
The peculiar orientation of LC molecules leads to spatial modulation of a cholesteric's refraction index, i.e. it changes harmonically. The light moving through such a structure diffracts. The feature of light propagation through a cholesteric LC is determined by the parameters of the helical orientation structure that depend on the properties of the liquid crystal and the nature of its interaction with the environment.
The scientists studied the structure of a cholesteric LC in droplets that were tens of microns in size and had perpendicular directors at the boundary with polymer. It turned out that the helical structure in various parts of droplets had different helix pitch, i.e. the distances at which the director made a complete turn.
"We've studied the structure formed in the droplets of a cholesteric LC in detail, and showed how the droplets look at different aspect directions and droplet sizes using an optical microscope. We've also studied the influence of an electric field on the periodicity structure and the shape of linear defects," said Mikhail Krakhalev, a co-author of the work, a candidate of physical and mathematical sciences, senior scientific associate of Kirensky Institute of Physics, and the dean of the Chair of General Physics at the Institute of Engineering Physics and Radio Electronics, SFU.
The scientists proved that a defect shaped as a twisted double helix is formed in cholesteric droplets. The authors also studied the optic textures of such structures that could be observed in an optical microscope. Given that the structures formed in cholesteric droplets are quite complex, respective optic textures are determined by a bigger number of factors.
"We've studied and described the correlation between the optical texture of the droplets and their size and the aspect directions. The described structures may help identify similar configurations in other systems, and the approach suggested by us may be used to analyze complex orientation structures," concluded Mikhail Krakhalev.